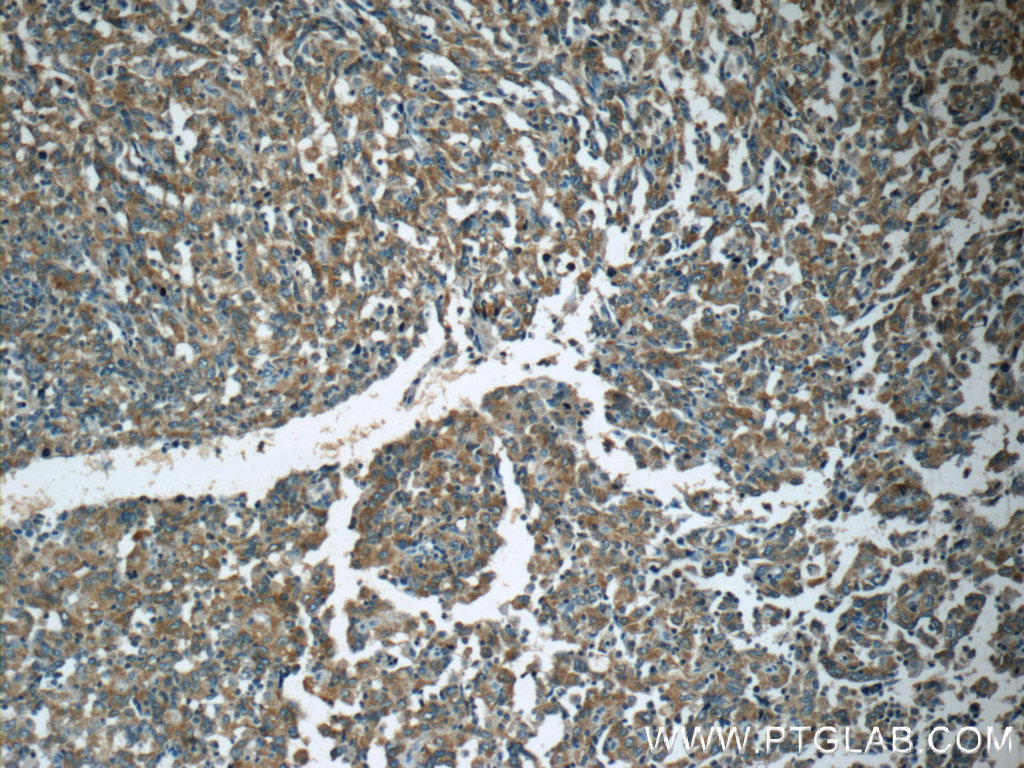

验证数据展示
经过测试的应用
| Positive IHC detected in | human breast cancer tissue, human colon tissue, human colon cancer tissue, human endometrial cancer tissue Note: suggested antigen retrieval with TE buffer pH 9.0; (*) Alternatively, antigen retrieval may be performed with citrate buffer pH 6.0 |
推荐稀释比
| 应用 | 推荐稀释比 |
|---|---|
| Immunohistochemistry (IHC) | IHC : 1:20-1:200 |
| It is recommended that this reagent should be titrated in each testing system to obtain optimal results. | |
| Sample-dependent, Check data in validation data gallery. | |
发表文章中的应用
| WB | See 9 publications below |
产品信息
19782-1-AP targets APC in WB, IHC, ELISA applications and shows reactivity with human samples.
| 经测试应用 | IHC, ELISA Application Description |
| 文献引用应用 | WB |
| 经测试反应性 | human |
| 文献引用反应性 | human, mouse |
| 免疫原 |
Peptide 种属同源性预测 |
| 宿主/亚型 | Rabbit / IgG |
| 抗体类别 | Polyclonal |
| 产品类型 | Antibody |
| 全称 | adenomatous polyposis coli |
| 别名 | adenomatous polyposis coli, APC, BTPS2, Deleted in polyposis 2.5, DP2, DP2.5, DP3, GS, Protein APC |
| 计算分子量 | 312 kDa |
| GenBank蛋白编号 | NM_000038 |
| 基因名称 | APC |
| Gene ID (NCBI) | 324 |
| RRID | AB_2878605 |
| 偶联类型 | Unconjugated |
| 形式 | Liquid |
| 纯化方式 | Antigen affinity purification |
| UNIPROT ID | P25054 |
| 储存缓冲液 | PBS with 0.02% sodium azide and 50% glycerol, pH 7.3. |
| 储存条件 | Store at -20°C. Stable for one year after shipment. Aliquoting is unnecessary for -20oC storage. |
背景介绍
APC, also named as DP2.5, belongs to the adenomatous polyposis coli (APC) family. APC is a tumor suppressor that regulates cell division, helps ensure that the number of chromosomes in a cell is correct following cell division, and associates with other proteins involved in cell attachment and signaling. APC promotes rapid degradation of CTNNB1 and participates in Wnt signaling as a negative regulator. It plays a critical role in several cellular processes. APC regulates beta-catenin levels through Wnt-signaling and is involved in actin cytoskeletal integrity, cell-cell adhesion and cell migration. APC activity is correlated with its phosphorylation state. Defects in APC are a cause of familial adenomatous polyposis (FAP) which includes also Gardner syndrome (GS). Defects in APC are a cause of hereditary desmoid disease (HDD) which also known as familial infiltrative fibromatosis (FIF). Defects in APC are a cause of medulloblastoma (MDB) which is a malignant, invasive embryonal tumor of the cerebellum with a preferential manifestation in children. Defects in APC are a cause of mismatch repair cancer syndrome (MMRCS) which also known as Turcot syndrome or brain tumor-polyposis syndrome 1 (BTPS1).
实验方案
| Product Specific Protocols | |
|---|---|
| IHC protocol for APC antibody 19782-1-AP | Download protocol |
| Standard Protocols | |
|---|---|
| Click here to view our Standard Protocols |
发表文章
| Species | Application | Title |
|---|---|---|
Biomed Pharmacother Glycogen phosphorylase B promotes ovarian cancer progression via Wnt/β-catenin signaling and is regulated by miR-133a-3p. | ||
World J Gastroenterol MiR-205 mediated APC regulation contributes to pancreatic cancer cell proliferation. | ||
Cancer Med MiR-26b suppresses hepatocellular carcinoma development by negatively regulating ZNRD1 and Wnt/β-catenin signaling. | ||
J Bone Oncol BAIAP2L2 promotes the proliferation, migration and invasion of osteosarcoma associated with the Wnt/β-catenin pathway | ||
Evid Based Complement Alternat Med Intervention Mechanism of Hunag-Lian Jie-Du Decoction on Canonical Wnt/β-Catenin Signaling Pathway in Psoriasis Mouse Model. |